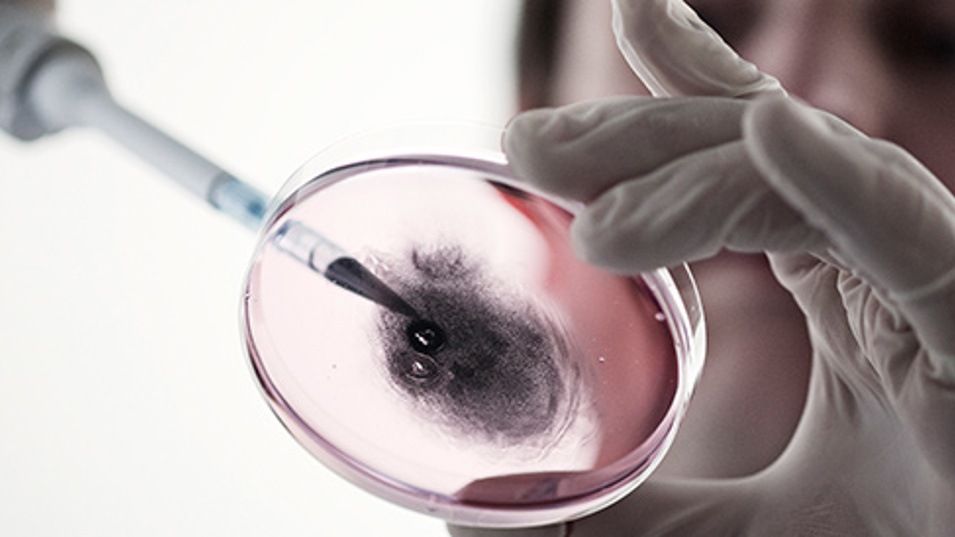

Lave koncentrationer af carbon black nanopartikler giver DNA-skader i muselunger
Det Nationale Forskningscenter for Arbejdsmiljø - 17-02-2015
Carbon black nanopartikler af typen Printex 90 øger forekomsten af DNA-strengbrud i lungevæv i mus. Det sker selv ved meget små doser.
Indånding af carbon black nanopartikler skader helbredet
Indånding af carbon black nanopartikler af typen Printex 90 medfører DNA-skader i lunger og lever - sandsynligvis på grund af dannelse af ROS (reaktive oxygenmolekyler). Derudover øger indånding af Printex 90 formentlig risikoen for hjertekarsygdom. Det viser resultater fra tidligere undersøgelser blandt andet af forskere fra NFA.
Sammenhæng mellem dosis og respons undersøgt
En af NFA’s tidligere undersøgelser viser, at mus får DNA-skader i lungerne, hvis de bliver udsat for, hvad der svarer til den mængde carbon black nanopartikler, mus vil indånde i løbet af 8 timer ved den danske grænseværdi for carbon black. Forskere fra NFA har nu undersøgt, om mus får DNA-skader, når de får deponeret Printex 90 nanopartikler i lungerne i lavere doser. Doserne var på henholdsvis 0,67, 2 og 6 µg Printex 90. Det svarer til, at musene blev udsat for Printex 90 i henholdsvis 20 minutter, 1 time og 3 timer ved samme koncentration som den gældende grænseværdi.
Brud på DNA-strenge og inflammation
Resultaterne viser blandt andet, at deponering af
- Printex 90 i lungerne på mus forårsagede en svag inflammation i lungerne. Inflammationen var forsvundet 28 dage efter deponeringen.
- Printex 90 i lungerne forårsagede en øget forekomst af DNA strengbrud i celler fra lungeskyllevæske fra mus 1, 3 og 28 dage efter deponeringen. Der var ingen sammenhæng mellem dosis og respons.
- 2 og 6 µg Printex 90 i lungerne forårsagede en øget forekomst af DNA strengbrud i lungevæv fra mus 28 dage efter lungedeponering.
Selv meget lave doser ser ud til at give DNA-skader
Ulla Vogel er professor på NFA og en af forskerne bag den nye undersøgelse. Hun siger:
”Vi betragter den øgede forekomst af brud på DNA-strenge som en indikation på, at der er en højere forekomst af skader på cellernes DNA og en højere aktivitet for at reparere skaderne, når mus får Printex 90 nanopartikler ned i lungerne. Det tyder med andre ord på, at Printex 90 nanopartikler giver DNA-skader selv ved lave doser. Det er derfor meget vigtigt at få klarlagt den biologiske mekanisme for, hvordan nogle nanopartikler fremkalder DNA strengbrud og DNA-skader.”
Læs den videnskabelige artikel
Kyjovska ZO, Jacobsen NR, Saber AT, Bengtson S, Jackson P, Wallin H & Vogel U. DNA damage following pulmonary exposure by instillation to low doses of carbon black (Printex 90) nanoparticles in mice. [Epub ahead of print]. Environmental and Molecular Mutagenesis 2014. Doi: 10.1002/em.21888
Fakta om undersøgelsen
- Undersøgelsen er gennemført af Dansk Center for Nanosikkerhed.
- Arbejdsmiljøforskningsfonden har støttet Dansk Center for Nanosikkerhed økonomisk.
Læs også
Yderligere oplysninger